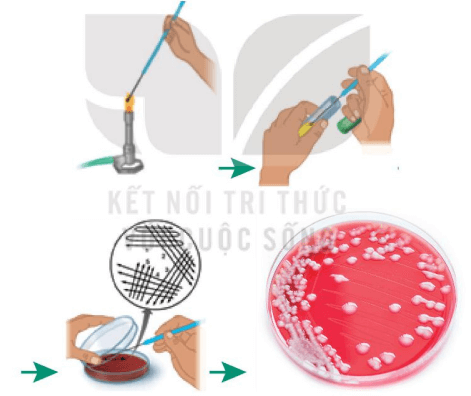
Lý thuyết Sinh 10 Kết nối tri thức Bài 20: Sự đa dạng và phương pháp nghiên cứu vi sinh vật
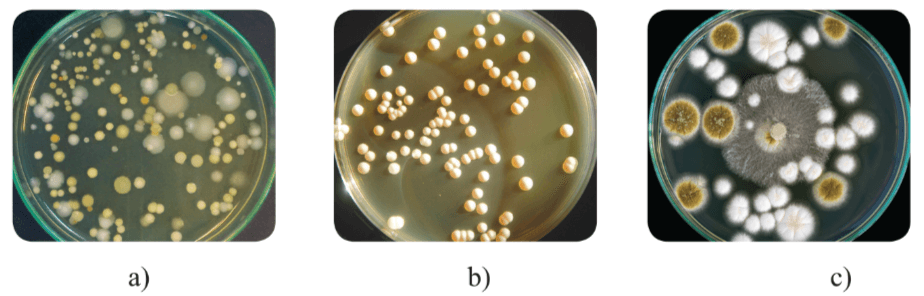
Lý thuyết Sinh 10 Kết nối tri thức Bài 20: Sự đa dạng và phương pháp nghiên cứu vi sinh vật

Lý thuyết Sinh học 10 bài 20 KNTT
Lý thuyết Sinh học lớp 10 bài 20: Sự đa dạng và phương pháp nghiên cứu vi sinh vật được VnDoc sưu tầm và tổng hợp các câu hỏi lí thuyết và trắc nghiệm có đáp án đi kèm nằm trong chương trình giảng dạy môn Sinh học lớp 10 sách KNTT. Mời quý thầy cô cùng các bạn tham khảo tài liệu dưới đây.
Sự đa dạng và phương pháp nghiên cứu vi sinh vật
I. Các nhóm vi sinh vật
- Khái niệm: Vi sinh vật là những kích thước nhỏ bé, thường chỉ quan sát được dưới kính hiển vi.

Một số vi khuẩn
- Phân loại: Dựa vào thành phần cấu tạo, vi sinh vật được chia thành 2 nhóm:
+ Vi sinh vật nhân sơ: gồm Archaea và vi khuẩn.
+ Vi sinh vật nhân thực: gồm vi sinh vật nhân thực đơn bào (nấm đơn bào, tảo đơn bào, động vật nguyên sinh) và vi sinh vật nhân thực đa bào (vi nấm, vi tảo và động vật đa bào kích thước hiển vi).

- Đặc điểm chung của vi sinh vật:
+ Kích thước nhỏ, thường chỉ quan sát được bằng kính hiển vi.
+ Đa số có cấu tạo đơn bào nhân sơ hoặc nhân thực.
+ Tốc độ chuyển hóa vật chất và năng lượng nhanh, sinh trưởng và sinh sản nhanh.
+ Số lượng nhiều: Trong các nhóm vi sinh vật, vi khuẩn là nhóm có số lượng lớn nhất (chiếm khoảng ½ sinh khối trên Trái Đất).
+ Phân bố rộng: phân bố gần như ở khắp mọi nơi trên Trái Đất và trên cơ thể sinh vật khác.

Một số vi sinh vật có khả năng chịu đựng được điều kiện khắc nghiệt
II. Các kiểu dinh dưỡng của vi sinh vật
- Dựa vào nguồn cung cấp năng lượng và nguồn carbon sử dụng, vi sinh vật có 4 kiểu dinh dưỡng là: Quang dị dưỡng, hóa dị dưỡng, quang tự dưỡng và hóa tự dưỡng.
|
Hình thức dinh dưỡng |
Nguồn năng lượng |
Nguồn carbon |
Các loại vi sinh vật điển hình |
|
Quang tự dưỡng |
Ánh sáng |
Chất vô cơ |
Vi sinh vật quang hợp (vi khuẩn lam, trùng roi, tảo) |
|
Hóa tự dưỡng |
Chất vô cơ |
Chất vô cơ |
Chỉ một số vi khuẩn và Archaea (vi khuẩn nitrate hóa, vi khuẩn oxy hóa hydrogen,...) |
|
Quang dị dưỡng |
Ánh sáng |
Chất hữu cơ |
Chỉ một số vi khuẩn và Archaea (vi khuẩn không lưu huỳnh màu lục và màu tía) |
|
Hóa dị dưỡng |
Chất hữu cơ |
Chất hữu cơ |
Nhiều vi khuẩn, nấm, động vật nguyên sinh |
Các kiểu dinh dưỡng ở vi sinh vật
III. Một số phương pháp nghiên cứu vi sinh vật
1. Phương pháp quan sát
- Phương pháp quan sát được sử dụng để nghiên cứu hình thái, kích thước và cấu tạo tế bào vi sinh vật.
- Để quan sát vi sinh vật, cần làm tiêu bản các tế bào vi sinh vật rồi đem soi dưới kính hiển vi quang học hoặc kính hiển vi điện tử.
- Một số phương pháp làm tiêu bản vi sinh vật:
|
Phương pháp |
Tiến hành |
Mục đích |
|
Soi tươi |
Dùng lam kính làm tiêu bản, sử dụng lamen để đậy lên các tiêu bản hoặc lam kính lõm → Thao tác đơn giản, tiến hành nhanh. |
Dùng để quan sát trạng thái sống, khả năng di động của vi khuẩn. |
|
Nhuộm đơn |
Nhuộm vi sinh vật một lần bằng thuốc nhuộm chuyên dụng như xanh methylene, tím kết tinh hoặc đỏ fuchsin để tăng độ tương pháp → Thao tác tương đối nhanh chóng. |
Dùng để kiểm tra sự hiện diện và đánh giá sơ bộ về hình ảnh, tính chất bắt màu, cách sắp xếp của vi khuẩn cũng như hình thái tế bào. |
|
Nhuộm Gram |
Nhuộm vi sinh vật bằng 4 loại thuốc nhuộm khác nhau: tím kết tinh, iodine, ethyl alcohol 95% và fuchsin. |
Dùng để phân biệt vi khuẩn Gr+ và Gr-. |
|
Soi tươi tìm Demodex gây viêm da |
Tiêu bản nhuộm đơn vi khuẩn |
|
Quy trình nhuộm Gram |
|
2. Phương pháp phân lập và nuôi cấy vi sinh vật
- Mục đích: Phương pháp phân lập, nuôi cấy vi sinh vật trên môi trường thạch được dùng để thu nhận vi sinh vật ở dạng thuần khiết, không lẫn với các loại vi sinh vật khác.
Nuôi cấy tạo khuẩn lạc vi khuẩn (mỗi đốm trắng trong đĩa thạch là một khuẩn lạc)
- Tiến hành: Mẫu vật chứa vi khuẩn hoặc vi nấm được pha loãng trong nước đã được tiệt trùng → Dùng dung dịch này phết lên bề mặt thạch đặc → Nuôi cấy để mỗi vi khuẩn phát triển tạo thành một khuẩn lạc riêng rẽ.
Khuẩn lạc vi sinh vật
- Khuẩn lạc là một tập hợp các tế bào được sinh ra từ một tế bào ban đầu trên môi trường thạch và có thể quan sát được bằng mắt thường. Khuẩn lạc có hình thái đặc trưng nên có thể dựa vào đó để phân biệt và tách riêng từng khuẩn lạc vi sinh vật cần nghiên cứu.
+ Khuẩn lạc vi khuẩn thường nhầy ướt, bề mặt thường dẹt và có nhiều màu sắc (trắng sữa, vàng, đỏ, hồng, cam,…), một số khuẩn lạc đặc biệt có dạng bột mịn.
+ Khuẩn lạc nấm men thường khô, tròn đều và lồi ở tâm, khuẩn lạc thường có màu trắng sữa.
+ Khuẩn lạc nấm mốc thường lan rộng do tế bào nấm mốc phát triển tạo thành dạng sợi dài, xốp, khuẩn lạc có nhiều màu sắc khác nhau như trắng, vàng, đen, xanh,…
IV. Trắc nghiệm bài Sự đa dạng và phương pháp nghiên cứu vi sinh vật
-----------------------------------------
Như vậy VnDoc đã giới thiệu các bạn tài liệu Lý thuyết Sinh học lớp 10 bài 20: Sự đa dạng và phương pháp nghiên cứu vi sinh vật. Mời các bạn tham khảo thêm tài liệu: Trắc nghiệm Sinh học 10, Giải bài tập Sinh học lớp 10, Giải Vở BT Sinh Học 10, Sinh học 10 Cánh Diều, Sinh học 10 Chân trời sáng tạo, Tài liệu học tập lớp 10.


